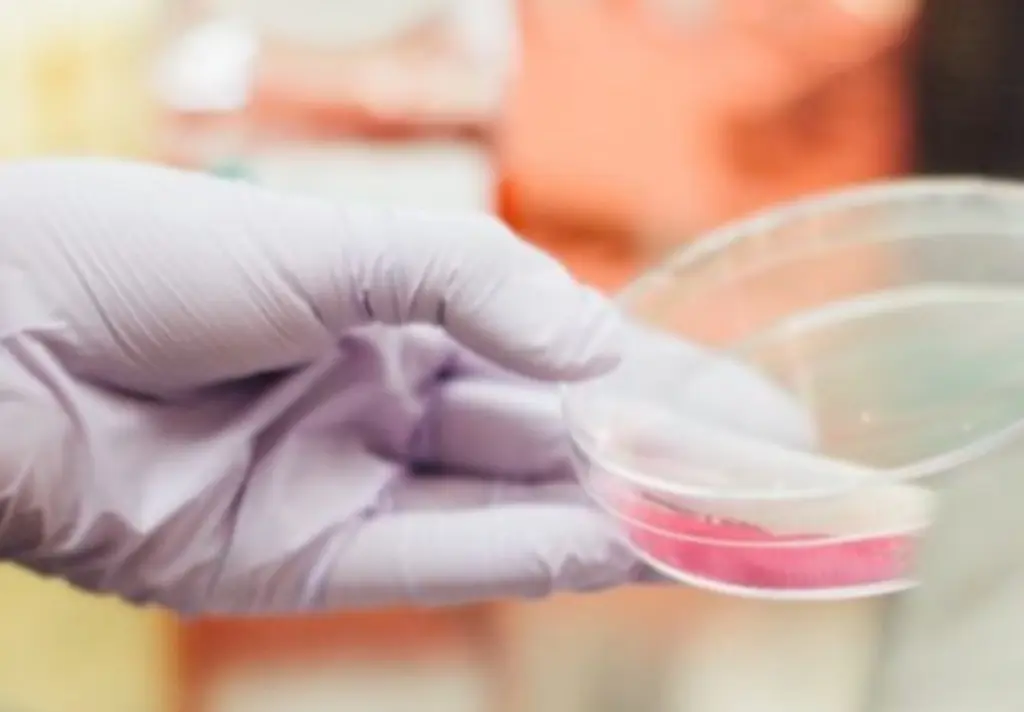
lab-oxidation Ozone Lab Oxidation Systems

Laboratory & Semiconductor Applications:
Ozone Lab Oxidation Systems
Ozone lab oxidation systems provide controlled ozone generation for a variety of laboratory and research applications. These systems can support cleaning and maintenance of equipment such as mixers, dryers, extractor hoods, cold rooms, and ovens, as well as work areas including benches, floors, and chambers. Additionally, ozone can be integrated into wastewater treatment processes, providing an alternative to traditional chemical treatments while supporting operational efficiency and safety.
Ozone for Semiconductor & ALD Processes
In the semiconductor and chip manufacturing industry, wafer cleaning, removal of metals and organic particles, photoresist stripping, and management of deionized water systems are critical steps. Ozone provides a controlled oxidation alternative to traditional cleaning methods, including sulfuric acid-peroxide treatments and RCA cleans (SC-1 and SC-2). Using ozone in these processes can support high-efficiency cleaning while reducing chemical consumption, lowering disposal costs, and enhancing operational sustainability.

Ozone Ultra-Pure
High-purity ozone can be used for many advanced applications. For example, in the microelectronics industry, the use of ultra pure ozone has been used for the growth of thin films in various deposition techniques. Absolute Ozone® can support this and many other applications by producing high purity ozone with lower oxygen consumption.

Ozone Ultra-high Concentration
In some advanced applications, it is necessary a high ozone concentration. Absolute Ozone® can support all these applications by producing high ozone concentrations with lower oxygen consumption.
Absolute Ozone® generators are a quantum leap in advancing ozone technology. Our generators can convert oxygen up to 350 g/Nm3 producing high concentration ozone up to 22% by weight higher. A high concentration means that more ozone is placed into the same volume of a reaction chamber speeding up the reaction and the processing time.

